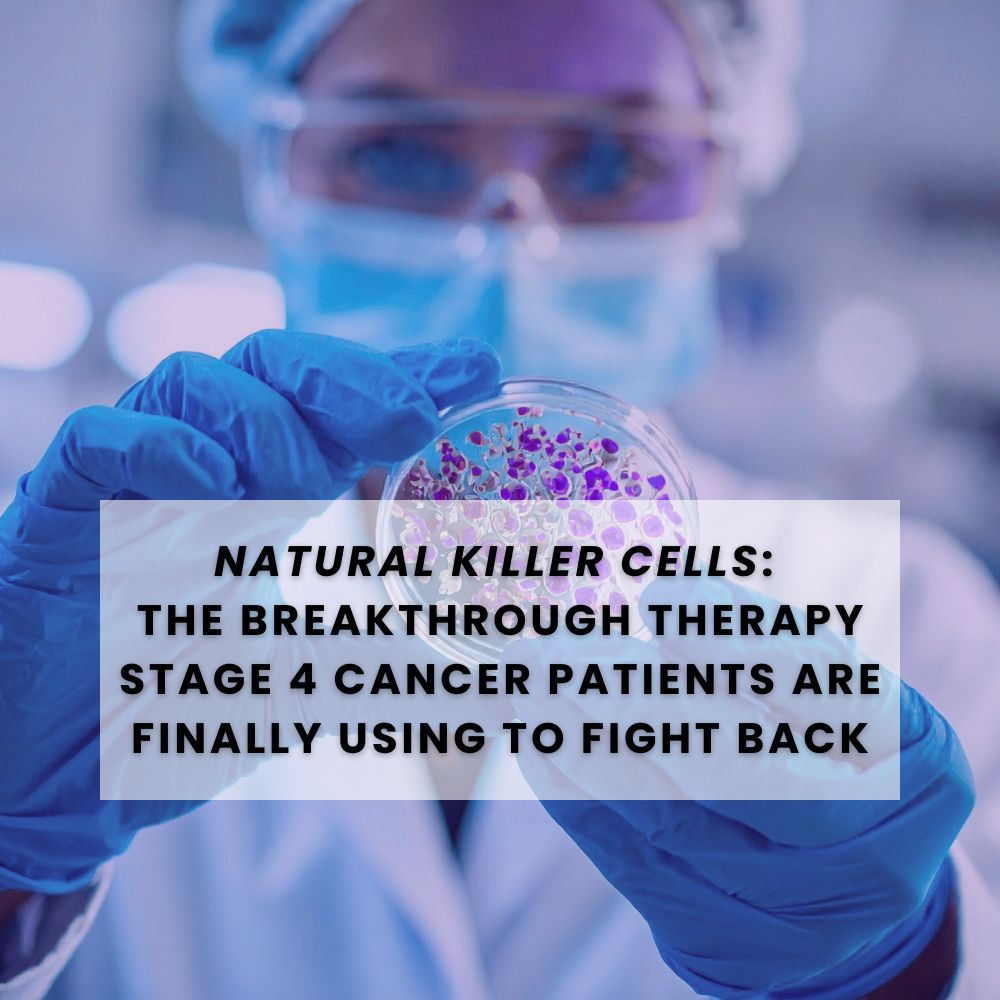
Natural Killer Cells: The Breakthrough Therapy Stage 4 Cancer Patients Are Finally Using to Fight Back

Cancer fights dirty. But now, the immune system fights back — intelligently
Every cancer patient remembers the moment they first heard the diagnosis.
But for those battling Stage 4 cancer, that moment often feels like a full stop — a point of no return.
Traditional medicine offers surgery, chemotherapy, and radiation — treatments that destroy as much as they save. Yet, amidst the fear and fatigue, a new weapon is emerging — one that doesn’t just fight cancer, but reawakens the body’s own ability to defend itself.
That weapon? Natural Killer (NK) Cells — the immune system’s elite defenders, now the centerpiece of a revolutionary advanced cancer therapy changing lives across the world.
At US Mexico Cancer Institute, this isn’t an experimental idea. It’s a proven, personalized therapy already helping patients with Stage 4 breast, lung, colon, pancreatic, and ovarian cancers reclaim hope — and results — once thought impossible.
As outlined in the institute’s transformative eBook “Natural Killer Cells – A Guide for Families and Loved Ones of Stage 4 Cancer Patients,” the story of NK Cell Therapy is not one of luck or chance — it’s the story of biology fighting back.
A Shift in Power — From Chemotherapy to Immunotherapy
For decades, cancer treatment has relied on external weapons: radiation, drugs, scalpels. But each came at a cost — a body weakened, an immune system shattered, and a spirit tested.
Natural Killer Cells Therapy changes that equation. It’s not about attacking the body to destroy cancer. It’s about strengthening the body so it can destroy cancer on its own.
This is the philosophy behind US Mexico Cancer Institute’s immunotherapy model — a science-driven, patient-centered approach that uses your body’s natural intelligence to find and eliminate cancer cells with precision.
NK cells are extracted from the patient’s own blood, expanded, and reactivated — creating a supercharged version of the immune system’s original defense mechanism. These powerful cells are then reintroduced into the bloodstream, where they target and kill cancer cells that have evaded chemotherapy and radiation.
It’s not just medicine — it’s immunologic warfare, reimagined for survival.
Turning Biology Into the Body’s Greatest Weapon
Imagine your immune system as a military.
T cells are the soldiers. B cells are the strategists.
But Natural Killer Cells — they’re the special forces. They don’t wait for orders. They detect, attack, and eliminate anything that threatens the body — from infected cells to malignant tumors — using an innate recognition system that no cancer can hide from.
In healthy individuals, these natural killer cells function quietly in the background, scanning for trouble. But in cancer patients, especially those with Stage 4 cancer, the immune system becomes exhausted, and NK cells lose their power.
US Mexico Cancer Institute restores that power. Through NK Cell Therapy, the patient’s own cells are multiplied to thousands of times their original count, rejuvenated, and trained to fight again. Once reinfused, they circulate through the body, hunting down cancer cells — with precision and zero toxicity.
It’s not just treatment — it’s the body’s rebellion against disease.
Real Stories, Real Science, Real Hope
At US Mexico Cancer Institute, science meets humanity.
This isn’t a factory-style clinic where patients are numbers — it’s a sanctuary of innovation and compassion.
Under the leadership of Dr. Ivan, a member of Mexico’s National Mesenchymal Stem Cell Council, the institute combines cutting-edge biotechnology with a five-star patient experience. Treatments are customized to each person’s condition, immune status, and goals — ensuring optimal outcomes for even the most advanced cases.
Patients often describe their experience not as “treatment,” but as transformation.
1. Defying the Odds: Natural Killer Cells in Stage 4 Colon Cancer Treatment
Stage 4 colon cancer is one of the hardest to treat with traditional methods. Yet, NK Cell Therapy offers new hope by enhancing immune surveillance and directly attacking colon cancer cells through precision targeting.
Through colon cancer immunotherapy, the NK cells penetrate tumor microenvironments that chemotherapy can’t reach, breaking down resistance barriers.
At US Mexico Cancer Institute, patients with late-stage colon cancer have seen improved immune response, reduced inflammation, and extended survival — outcomes that redefine what’s possible in stage 4 colon cancer treatment.
Go deeper into personalized cancer treatment options → Defying the Odds: Natural Killer Cells in Stage 4 Colon Cancer Treatment
2. The Role of Natural Killer Cells in Fighting Hidden Tumors in Stage 4 Ovarian Cancer
Ovarian cancer has long been called “the silent killer” because it often goes undetected until the late stages. But NK cells are uniquely built for stealth detection.
In stage 4 ovarian cancer treatment, ovarian cancer immunotherapy using NK cells boosts the immune system’s ability to locate hidden tumor clusters and inhibit their spread.
This natural intelligence — paired with the Institute’s luxury care environment — allows patients to focus not on fear, but on healing, supported by world-class expertise and personalized therapy.
See the full guide on innovative therapy → The Role of Natural Killer Cells in Fighting Hidden Tumors in Stage 4 Ovarian Cancer
3. Stage 4 Lung Cancer: How Natural Killer Cells Are Giving Families Real Hope
For stage 4 lung cancer patients, breathing can feel like a daily battle. NK Cell Therapy offers a new frontier.
Unlike chemotherapy, which damages both cancerous and healthy cells, NK cells selectively target malignant cells while preserving healthy lung tissue. This reduces side effects and allows faster recovery.
The US Mexico Cancer Institute’s lung cancer therapy protocols integrate immunotherapy for lung cancer with nutritional and detox support — a holistic approach that enhances strength and resilience throughout treatment.
Families report something rare in late-stage cancer care: hope grounded in results.
Connect this insight to your next step in healing → Stage 4 Lung Cancer: How Natural Killer Cells Are Giving Families Real Hope
4. Natural Killer Cells Therapy Revolutionizes Stage 4 Pancreatic Cancer Treatment
Pancreatic cancer is infamous for its resistance to chemotherapy. But the rules are changing.
Through immunotherapy for pancreatic cancer, NK cells are trained to recognize and kill resistant cancer cells that conventional treatments cannot reach. By restoring the immune system’s ability to detect hidden tumors, stage 4 pancreatic cancer therapy has become not just possible — but promising.
The institute’s success in combining NK Cell Therapy with advanced detoxification and cellular rejuvenation techniques is giving patients longer, stronger, and better-quality lives.
Understand how our integrative care works together → Natural Killer Cells Therapy Revolutionizes Stage 4 Pancreatic Cancer Treatment
5. Natural Killer Cells Extending Lives in Stage 4 Breast Cancer
For many women facing stage 4 breast cancer, traditional treatments often mean endless cycles of pain and exhaustion. But immunotherapy for breast cancer with NK cells offers a gentler, smarter path.
At US Mexico Cancer Institute, each patient’s NK cells are cultivated to restore the body’s ability to fight breast cancer stage 4 therapy naturally. Results often include reduced tumor load, improved energy, and restored emotional well-being — all without the toxicity of chemotherapy.
It’s not just surviving — it’s reclaiming life on your own terms.
See how this therapy fits into advanced cancer care → Natural Killer Cells Extending Lives in Stage 4 Breast Cancer

A Higher Standard of Cancer Care
The difference at US Mexico Cancer Institute goes far beyond the lab.
From the first phone call to the last follow-up, patients experience what true medical hospitality feels like.
The institute’s white-glove medical tourism experience includes private airport transfers, bilingual patient coordination and luxury accommodations.
Each therapy is designed for comfort, safety, and transparency.
Unlike conventional facilities, the Institute isn’t built around fear — it’s built around trust, dignity, and empowerment.
The Future of Cancer Treatment Is Already Here
In the U.S., many of these therapies are still waiting for approval.
In Mexico, they’re already saving lives.
At US Mexico Cancer Institute, the future of cancer treatment isn’t theoretical — it’s happening every day. Through Natural Killer Cells Therapy, patients are proving that the human body, when properly guided, is still the most powerful healer known to science.
As the eBook “Natural Killer Cells – A Guide for Families and Loved Ones of Stage 4 Cancer Patients” concludes:
“NK cells are not a miracle. They’re biology at its best — a reminder that the cure may have been inside us all along.”
This isn’t just about fighting cancer. It’s about fighting back with intelligence, precision, and hope.
Because when cancer fights dirty — it’s time to fight smarter.
Frequently Asked Questions
1. What are Natural Killer Cells?
Natural Killer Cells are part of the body’s immune system. They identify and destroy abnormal cells, such as tumors, without prior exposure — making them the first line of defense against cancer.
2. How does Natural Killer Cells Therapy work?
The therapy involves extracting a patient’s NK cells, multiplying and activating them in a certified lab, and reinfusing them into the body to enhance immune defense and target cancer cells.
3. Is NK Cell Therapy safe?
Yes. All treatments at US Mexico Cancer Institute follow COFEPRIS-certified standards with thorough testing for purity, safety, and effectiveness.
4. What types of cancer can NK Cell Therapy treat?
NK Cell Therapy has shown positive results in stage 4 colon, breast, ovarian, pancreatic, and lung cancers, as well as other solid tumors and blood cancers.
5. Why choose treatment in Mexico?
Mexico’s medical innovation framework allows access to advanced, ethical, and regulated therapies that are still restricted elsewhere — often at a more affordable cost, without sacrificing quality or care.

Turning Fear into Empowerment
For many, cancer was once the end of the story.
Now, it’s just the turning point.
Natural Killer Cells Therapy is more than science — it’s the embodiment of hope, compassion, and modern medical intelligence. And US Mexico Cancer Institute stands as the bridge between possibility and proof — where patients are no longer just fighting cancer… they’re finally winning.
If you or your loved one is searching for a second chance — the future of healing is already here.
- Tumor Immune Response 6 Documented Immune Changes Seen During Cancer Growth - May 26, 2026
- Immunotherapy Sessions 5 Missed Treatment Steps That Can Affect Patient Readiness - May 19, 2026
- How Immunotherapy Works 7 Proven Immune Changes Families Should Understand Before Treatment Starts - May 15, 2026




